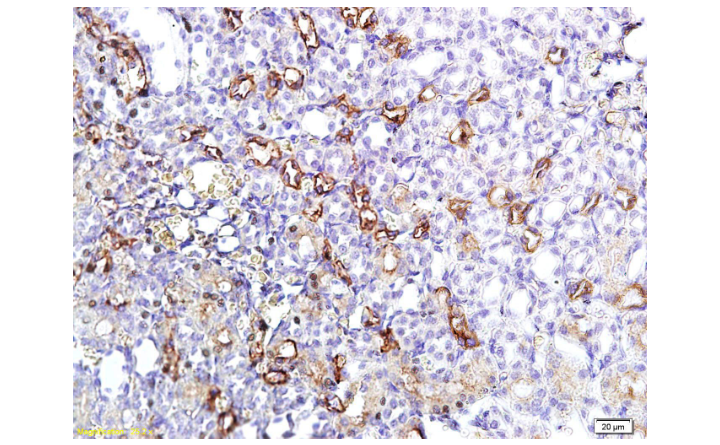

Sample:
Lane 1: Raw264.7 (Mouse) Cell Lysate at 30 ug
Lane 2: HL60 (Human) Cell Lysate at 30 ug
Primary: Anti-EMR1/ F4/80 (bs-11182R) at 1/1000 dilution
Secondary: IRDye800CW Goat Anti-Rabbit IgG at 1/20000 dilution
Predicted band size: 100-110 kD
Observed band size: 125 kD
表皮生长因子样激素受体1(EMR1)抗体
ADGRE1 Rabbit pAb
- bs-11182R
- 北京博奥森
- 北京市
- 现货
- 50ul
- 100ul
- 200ul
- 议价
- 2023-10-16 14:29:41
北京博奥森生物技术有限公司
一键申请试用
咨询
加入意向单
联系方式
- 英文名称
- ADGRE1 Rabbit pAb
概述
产品编号
bs-11182R
产品分类
一抗
产品类型
质检1级
英文名称
ADGRE1 Rabbit pAb
中文名称
表皮生长因子样激素受体1(EMR1)抗体
英文别名
F4/80; Adhesion G protein-coupled receptor E1; Cell surface glycoprotein EMR1; Cell surface glycoprotein F4/80; DD7A5 7; Egf like module containing mucin like hormone receptor like 1; Egf like module containing mucin like hormone receptor like sequence 1; EGF like module receptor 1; EGF TM7; EGF-like module receptor 1; EGF-like module-containing mucin-like hormone receptor-like 1; EGFTM7; EMR 1; EMR1; EMR-1; EMR1 hormone receptor; EMR1_HUMAN; AGRE1_HUMAN; Gpf480; Ly71; Lymphocyte antigen 71; TM7LN3.
交叉反应
Human,Mouse(predicted:Rat)
抗体来源
Rabbit
免疫原
KLH conjugated synthetic peptide derived from human ADGRE1
亚型
IgG
纯化方法
affinity purified by Protein A
克隆类型
Polyclonal
理论分子量
95kDa
浓度
1mg/ml
储存液
0.01M TBS(pH7.4) with 1% BSA, 0.03% Proclin300 and 50% Glycerol.
保存条件
Shipped at 4℃. Store at -20 °C for one year. Avoid repeated freeze/thaw cycles.
功能
Could be involved in cell-cell interactions.
亚基
Belongs to the G-protein coupled receptor 2 family. LN-TM7 subfamily. Contains 6 EGF-like domains. Contains 1 GPS domain.
亚细胞定位
Cell membrane.
组织特异性
Wide expression; increased levels in peripheral blood mononuclear cells.
相似性
Belongs to the G-protein coupled receptor 2 family. LN-TM7 subfamily.
Contains 6 EGF-like domains.
Contains 1 GPS domain.
Contains 6 EGF-like domains.
Contains 1 GPS domain.
数据库链接
Entrez Gene: 2015 Human
Entrez Gene: 13733 Mouse
Omim: 600493 Human
SwissProt: Q14246 Human
SwissProt: Q61549 Mouse
Unigene: 2375 Human
Unigene: 2254 Mouse
背景资料
The epidermal growth factor (EGF)-TM7 family constitutes a group of class B G-protein coupled receptors, which includes CD97, EMR1 (EGF-like molecule containing mucin-like hormone receptor 1, designated F4/80 in mouse), EMR2, EMR3, FIRE, and ETL (1–3). These family members are characterized by an extended extracellular region with several N-terminal EGF domains, and are predominantly expressed on cells of the immune system (1–3). The EGF-TM7 protein family are encoded by a gene cluster on human chromosome 19p13 (1,3,4). The F4/80 molecule is solely expressed on the surface of macrophages and serves as a marker for mature macrophage tissues, including Kupffer cells in liver, splenic red pulp macrophages, brain microglia, gut lamina propria, and Langerhans cells in the skin (1). F4/80/EMR1 undergoes extensive N-linked glycosylation as well as some O-linked glycosylation (5,6). The function of F4/80/EMR1 is unclear, but it is speculated to be involved in macrophage adhesion events, cell migration, or as a G-protein coupled signaling component of macrophages.
应用
| 应用 | 推荐稀释比例 |
|---|---|
| ELISA | 1:5000-10000 |
| WB | 1:500-2000 |
图片资料